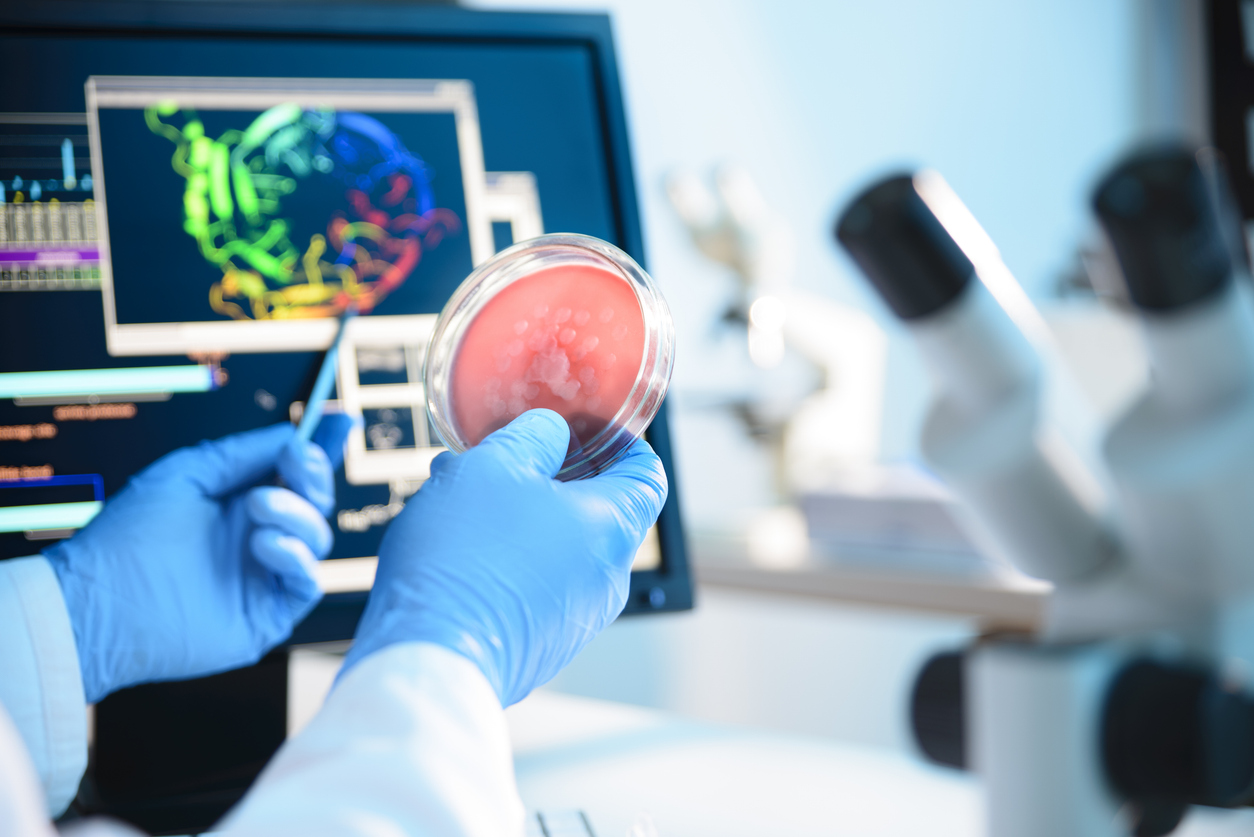
Fungal monitoring software

We built a cross-platform application that works on Windows and Linux. It also interfaces with the electronic microscope, which is connected through USB. Computer vision algorithms are directing the microscope to move and zoom in and out.
Our solution democratizes sample analysis by allowing someone without specialized education or training to walk through an area and manually collect biosamples, such as fallen leaves, into specialized tubes before placing them into the device that runs our AI-powered app.
Next, this AI system works as follows:
●
Computer vision algorithms direct the microscope to optimize sample scanning without human intervention
●
If an infection is detected, TensorFlow models classify infections and predict spread rates using temporal data (e.g., changes between weekly samples)
●
The system builds fungal maps, visualizing microbe colonies on plants and surrounding areas
●
It offers pollution tracking functionality as it generates heatmaps of infected areas across regions and timestamps outbreaks
●
The AI-driven recommendation engine suggests containment measures (e.g., targeted pesticides) based on infection type and spread patterns
Our solution can scale monitoring efforts by allowing researchers to analyze samples twice a week, or more frequently if needed.